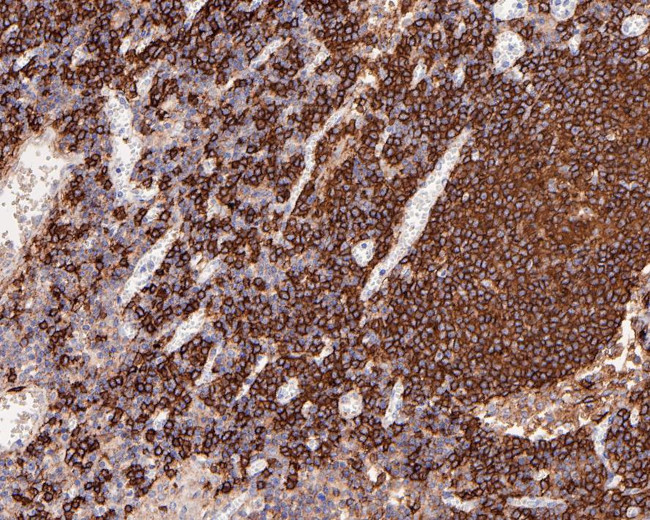
CD20 Antibody in Immunohistochemistry (Paraffin) (IHC (P))

Search
Invitrogen
CD20 Recombinant Rabbit Monoclonal Antibody (PD00-02)
{{$productOrderCtrl.translations['antibody.pdp.commerceCard.promotion.promotions']}}
{{$productOrderCtrl.translations['antibody.pdp.commerceCard.promotion.viewpromo']}}
{{$productOrderCtrl.translations['antibody.pdp.commerceCard.promotion.promocode']}}: {{promo.promoCode}} {{promo.promoTitle}} {{promo.promoDescription}}. {{$productOrderCtrl.translations['antibody.pdp.commerceCard.promotion.learnmore']}}
图: 1 / 3
CD20 Antibody (MA5-44672) in IHC (P)



产品信息
MA5-44672
种属反应
宿主/亚型
Expression System
分类
类型
克隆号
抗原
偶联物
形式
浓度
规格
纯化类型
保存液
内含物
保存条件
运输条件
RRID
靶标信息
CD20 is a non-glycosylated surface phosphoprotein that has a molecular weight range of 33-37 kDa depending on the degree of phosphorylation. CD20 is expressed on mature and most malignant B cells, in a subpopulation of T lymphocytes and follicular dendritic cells. CD20 expression on B cells is synchronous with the expression of surface IgM and it regulates transmembrane calcium conductance, cell cycle progression and B-cell proliferation. CD20 is also associated with lipid rafts, but the intensity of this association depends on extracellular triggering, employing CD20 conformational change, and/or BCR (B cell antigen receptor) aggregation. After the receptor ligation, BCR and CD20 colocalize and then rapidly dissociate before BCR endocytosis, whereas CD20 remains at the cell surface. CD20 serves as a useful target for antibody-mediated therapeutic depletion of B cells, as it is expressed at high levels on most B-cell malignancies, but does not become internalized or shed from the plasma membrane following monoclonal antibody treatment. Diseases associated with CD20 dysfunction include Ms4a1-related common variable immune deficiency.
仅用于科研。不用于诊断过程。未经明确授权不得转售。
篇参考文献 (0)
生物信息学
蛋白别名: APY; ATOPY; B-lymphocyte antigen CD20; B-lymphocyte cell-surface antigen B1; B-lymphocyte surface antigen B1; Bp35; CD20; CD20 antigen; CD20 receptor; Fc epsilon receptor I beta chain; Fc Fragment of IgE high affinity I receptor for beta polypeptide; FCER1B; High affinity immunoglobulin epsilon receptor subunit beta; IgE Fc receptor subunit beta; IGEL; IGER; IGHER; LEU16; Leukocyte surface antigen Leu-16; Ly44; Membrane-spanning 4-domains subfamily A member 1; membrane-spanning 4-domains, subfamily A, member 1; MGC3969; unnamed protein product
基因别名: B1; Bp35; CD20; CVID5; FMC7; LEU-16; MS4A1; S7
UniProt ID: (Human) P11836
Entrez Gene ID: (Human) 931